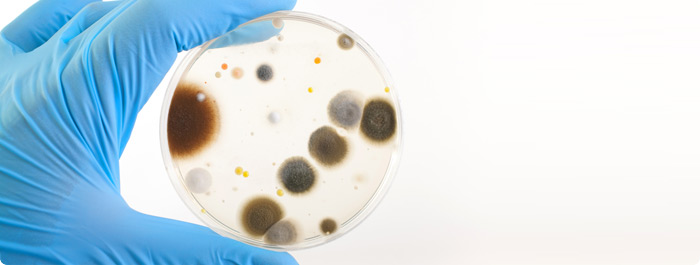

เบต้า-แลคแทม (Beta-Lactam antibiotic)
- โดย เภสัชกร อภัย ราษฎรวิจิตร
- 9 มกราคม 2565
- Tweet
สารบัญ
- บทนำ :คือยาอะไร?
- ยาเบต้า-แลคแทมมีสรรพคุณ (คุณสมบัติ)รักษาโรคอะไร?
- ยาเบต้า-แลคแทมมีกลไกการออกฤทธิ์อย่างไร?
- ยาเบต้า-แลคแทมมีรูปแบบการจัดจำหน่ายอย่างไร?
- ยาเบต้า-แลคแทมมีขนาดรับประทานอย่างไร?
- เมื่อมีการสั่งยาควรแจ้งแพทย์/พยาบาลและเภสัชกรอย่างไร?
- หากลืมรับประทานยาควรทำอย่างไร?
- ยาเบต้า-แลคแทมมีผลไม่พึงประสงค์อย่างไร?
- มีข้อควรระวังการใช้ยาเบต้า-แลคแทมอย่างไร?
- ยาเบต้า-แลคแทมมีปฏิกิริยาระหว่างยากับยาตัวอื่นอย่างไร?
- ควรเก็บรักษายาเบต้า-แลคแทมอย่างไร?
- ยาเบต้า-แลคแทมมีชื่ออื่นอีกไหม? ผลิตจากบริษัทอะไรบ้าง?
- บรรณานุกรม
บทความที่เกี่ยวข้อง
- ยารักษาโรค (Pharmaceutical drug)
- ข้อปฏิบัติพื้นฐานในการใช้ยาทุกชนิด
- โรคติดเชื้อ ภาวะติดเชื้อ (Infectious disease)
- ยาปฏิชีวนะ (Antibiotics)
- แบคทีเรีย: โรคจากแบคทีเรีย (Bacterial infection)
- เชื้อไวรัส โรคติดเชื้อไวรัส (Viral infection)
- เชื้อดื้อยา ซูเปอร์บั๊ก (Superbug)
- การคุมกำเนิด (Contraception)
บทนำ :คือยาอะไร?
นักวิทยาศาสตร์เรียกยาปฏิชีวนะ (Antibiotic)ที่มีส่วนประกอบทางเคมีของสารที่ใช้ฆ่าแบคทีเรียที่เรียกว่า เบต้า-แลคแทม (Beta –lactam) ว่า “ยาปฏิชีวนะ เบต้า- แลคแทม หรือยาเบต้า-แลค แทม หรือยาเบต้า-แลคแทม แอนไทไบโอติก (Beta-lactam antibiotic)” ซึ่งต่อไปในบทความนี้ขอเรียกว่า “เบต้า-แลคแทม”
ยากลุ่มนี้จะมีฤทธิ์ต่อต้านเชื้อแบคทีเรียได้หลายชนิด และจัดเป็นยาที่มีจำหน่ายในแทบทุกพื้น ที่ของหลายประเทศทั่วโลกรวมถึงประเทศไทยของเราด้วย อาจแบ่งกลุ่มยาเบต้า-แลคแทม แอนไท ไบโอติคออกเป็นหมวดหมู่ย่อยได้อีกดังนี้
- Penams: เป็นกลุ่มของยาปฏิชีวนะในกลุ่ม Penicillin ที่มีการออกฤทธิ์แคบ (Narrow spectrum antibiotic รักษาได้เฉพาะโรคที่เกิดจากแบคทีเรียบางชนิด) ไปจนกระทั่งออกฤทธิ์กว้าง (Broad spectrum antibiotic รักษาได้ครอบคลุมโรคที่เกิดจากแบคทีเรียหลากหลายชนิด) ประกอบด้วยตัวยา ดังนี้เช่น Benzathine penicillin, Benzyl penicillin, Phenoxymethyl penicillin, Procaine penicillin, Cloxacillin, Dicloxacillin, Flucloxacillin, Methicillin, Nafcillin, Oxacillin, Temocillin, Amoxicillin, Ampicillin, Co-amoxiclav (Amoxicillin & clavulanic acid), Mecillinam, Carbenicillin, Ticarcillin, Azlocillin, Mezlocillin, และ Piperacillin
- Cephems: เป็นกลุ่มยาปฏิชีวนะที่มักจะรู้จักกันในชื่อ Cephalosporin, Cephamycin, และ Cephem โดยจะมีโครงสร้างทางเคมีแตกต่างกันออกไปเล็กน้อย ยากลุ่มนี้สามารถออกฤทธิ์ต้านเชื้อแบคทีเรียได้ในระดับกลางๆจนถึงระดับกว้าง ประกอบด้วยตัวยาดังนี้เช่น Cefazolin, Cephalexin, Cephalosporin C, Cephalothin, Cefaclor, Cefamandole, Cefuroxime, Cefotetan, Cefoxitin, Cefixime, Cefotaxime, Cefpodoxime, Ceftazidime, Ceftriaxone, Cefepime, Cefpirome, Ceftobiprole เป็นต้น
3. Carbapenems และ Penems: จัดเป็นยาที่ออกฤทธิ์ในระดับกว้างที่สุด ประกอบด้วยตัวยาดังนี้เช่น Biapenem, Doripenem, Ertapenem, Faropenem, Imipenem, Meropenem, Panipenem, Razupenem, Tebipenem, Thienamycin - Monobactams: เป็นกลุ่มยาที่ออกฤทธิ์ต่อเชื้อแบคทีเรียแกรมลบหรือที่เรียกว่า Aerobic gram negative bacteria ประกอบด้วยตัวยาดังนี้เช่น Aztreonam, Tigemonam, Nocardicin A, Tabtoxinine β-lactam
- Beta-Lactamase inhibitors จัดเป็นยาปฏิชีวนะที่ขยายผลในการต่อต้านแบคทีเรีย กล่าวคือ ยา กลุ่มนี้จะยับยั้งการทำงานของเอนไซม์ที่มีชื่อว่า เบต้า-แลคแทมเมส (Beta lactamase) ซึ่งเป็นเอน ไซม์ที่แบคทีเรียสร้างขึ้นมาเพื่อต่อต้านฤทธิ์ของยาปฏิชีวนะ ตัวยาในหมวดนี้ประกอบด้วย Clavulanic acid, Tazobactam, และ Sulbactam
ยาเบต้า-แลคแทมมีสรรพคุณ (คุณสมบัติ) อย่างไร?
ยาเบต้า-แลคแทมมีสรรพคุณ/ข้อบ่งใช้:
- ใช้ป้องกันและบำบัดรักษาอาการป่วยเนื่องมาจากการติดเชื้อแบคทีเรียชนิดแกรมบวกเป็นหลัก และปัจจุบันได้พัฒนาไปถึงขั้นต่อต้านแบคทีเรียที่เป็นชนิดแกรมลบได้แล้ว
ยาเบต้า-แลคแทมมีกลไกการออกฤทธิ์อย่างไร?
ยากลุ่มเบต้า-แลคแทมจะออกฤทธิ์ยับยั้งการสร้างผนังเซลล์(เซลล์-เนื้อเยื่อ-อวัยวะ)ของเชื้อแบคทีเรีย ทำให้แบคทีเรียหยุดการเจริญเติบโตและตายลงในที่สุด จึงเป็นเหตุผลของฤทธิ์ในการรักษาตามสรรพคุณ
ยาเบต้า-แลคแทมมีรูปแบบการจัดจำหน่ายอย่างไร?
ยาเบต้า-แลคแทมมีรูปแบบการจัดจำหน่าย เช่น
- ยาเม็ด ขนาด 375, 625, 1000 มิลลิกรัม/เม็ด
- ยาแคปซูล ขนาด 250, 500 มิลลิกรัม/แคปซูล
- ยาน้ำ ขนาด 125,25, 228.5, 312.5, 457 มิลลิกรัม/5 มิลลิลิตร
- ยาฉีดที่มีลักษณะเป็นผงแห้งขนาด 1,2 และ 5 ล้านยูนิต/ขวด(ใช้ละลายในน้ำกลั่นปริมาณตามที่ระบุในเอกสารกำกับยา)
- ยาฉีดที่มีลักษณะเป็นผงแห้งขนาด 1,2 กรัม/ขวด
ยาเบต้า-แลคแทมมีขนาดรับประทานอย่างไร?
ด้วยในกลุ่มยาเบต้า-แลคแทมมีหลายรายการ ขนาดรับประทานจึงขึ้นกับการพิจารณาของแพทย์ โดยต้องอาศัยข้อมูลของตัวผู้ป่วย (เช่น อาการ อายุ โรคประจำตัว ชนิดของเชื้อแบคทีเรีย) รวมกับเลือกใช้ยาให้ตรงตามอาการและให้มีความปลอดภัยมากที่สุด ซึ่งที่สำคัญต้องรับประทานยาตามแพทย์สั่งจนครบถึงแม้อาการจะดีขึ้น (ไม่หยุดยาเองเมื่ออาการดีขึ้น) ทั้งนี้เพื่อป้องกันการดื้อยาของเชื้อแบคทีเรีย ดังนั้นการรับประทานจึงต้องเป็นไปตามคำสั่งของแพทย์ผู้รักษาเท่านั้น
เมื่อมีการสั่งยาควรแจ้งแพทย์/พยาบาลและเภสัชกรอย่างไร?
เมื่อมีการสั่งยาทุกชนิดที่รวมถึงยาเบต้า-แลคแทม ผู้ป่วยควรแจ้ง แพทย์ พยาบาล และเภสัชกร เช่น
- ประวัติแพ้ยาทุกชนิด เช่น กินยา/ใช้ยาแล้ว คลื่นไส้มาก ขึ้นผื่น หรือแน่นหายใจติดขัด/หายใจลำบาก /หอบเหนื่อย
- มีโรคประจำตัวต่างๆ รวมทั้งกำลังกินยา/ใช้ยาอะไรอยู่ เพราะยาเบต้า-แลคแทมอาจส่งผลให้อาการของโรคเหล่านั้นรุนแรงขึ้น หรืออาจเกิดปฏิกิริยาระหว่างยากับยาอื่นๆที่กินอยู่ก่อน
- หากเป็นสุภาพสตรีควรแจ้งว่าอยู่ในภาวะตั้งครรภ์/มีครรภ์หรือกำลังให้นมบุตร เพราะยาหลายประเภทสามารถผ่านทางน้ำนมหรือรก และเข้าสู่ทารก จนก่อให้เกิดผลข้างเคียงได้
หากลืมรับประทานยาควรทำอย่างไร?
หากลืมรับประทานยาเบต้า-แลคแทม สามารถรับประทานเมื่อนึกขึ้นได้ ถ้าเวลาใกล้เคียงกับการรับประทานยาในมื้อถัดไป ไม่จำเป็นต้องเพิ่มปริมาณยาเป็น 2 เท่า
ยาเบต้า-แลคแทมมีผลไม่พึงประสงค์อย่างไร?
ยาในกลุ่มเบต้า-แลคแทม สามารถก่อให้เกิดผล/ อาการไม่พึงประสงค์จากการใช้ยา (ผลข้างเคียง/อาการข้างเคียง) เช่น
- มีอาการท้องเสีย
- คลื่นไส้
- ผื่นคัน
- อาจทำให้เกิดโรคเชื้อรากลุ่มแคนดิดา(Candida/โรคแคนดิไดอะซิส)ในผู้ป่วยได้
- อาจมี
- ไข้
- ลมพิษ
- อาเจียน
- ผื่นผิวหนังอักเสบ
- ลำไส้ใหญ่อักเสบ
- ชัก
- หากเป็นพวกยาฉีด อาจทำให้เกิด อาการปวด และอักเสบในบริเวณที่มีการฉีดยา
*นอกจากนี้ผู้ป่วยบางรายอาจมีอาการแพ้ยา โดยแพ้ข้ามกลุ่มยาได้ด้วย เช่น เคยแพ้ยาเพนิซิลลิน (Penicillin) ก็อาจแพ้ยาเซฟาโลสปอริน (Cephalosporin) ได้เช่นกัน ด้วยยากลุ่มเบต้า-แลคแทม มีโครงสร้างทางเคมีที่ใกล้เคียงกัน
มีข้อควรระวังการใช้ยาเบต้า-แลคแทมอย่างไร?
มีข้อควรระวังการใช้ยาเบต้า-แลคแทม เช่น
- ห้ามใช้กับผู้ที่แพ้ยาในกลุ่มนี้
- ระวังการใช้ยานี้กับผู้ป่วยโรคไต
- ก่อนการจ่ายยานี้ให้กับผู้ป่วย ควรต้องสอบถามผู้ป่วยว่ามีประวัติการแพ้ยากลุ่มเบต้า-แลคแทมหรือไม่
- ระวังการใช้ยานี้ในสตรีตั้งครรภ์ สตรีที่อยู่ในภาวะให้นมบุตร เด็ก(นิยามคำว่าเด็ก) และผู้สูงอายุ
- การใช้ยากลุ่มนี้ไปนานๆ ควรต้องระวังเรื่องลำไส้ใหญ่อักเสบ อันเนื่องจากเชื้อแบคทีเรียประจำถิ่น ชนิด Clostridium difficile ที่อาจมีการเจริญเติบโตอย่างรวดเร็วเกินปกติจนสามารถก่อโรคได้
- ผู้ป่วยต้องรับประทานยานี้ต่อเนื่องจนครบตามแพทย์สั่ง เพราะการหยุดยาเองอาจทำให้เกิดเชื้อดื้อยาได้
- ห้ามแบ่งยาให้ผู้อื่นใช้
- ห้ามใช้ยาหมดอายุ
- ห้ามเก็บยาหมดอายุ
***** อนึ่ง ทุกคนต้องตระหนักถึงความปลอดภัยจากการใช้ ”ยา” ที่รวมถึงยาแผนปัจจุบันทุกชนิด (รวมยาเบต้า-แลคแทมด้วย) ยาแผนโบราณทุกชนิด อาหารเสริม ผลิตภัณฑ์เสริมอาหาร และสมุนไพรต่างๆเสมอ เพราะยามีทั้งให้คุณและให้โทษ ดังนั้นเมื่อมีการใช้ยาทุกครั้ง ควรต้องปฏิบัติตามข้อปฏิบัติพื้นฐานในการใช้ยาทุกชนิดเสมอ (อ่านเพิ่มเติมได้ในเว็บ haamor.com บทความเรื่อง ข้อปฏิบัติพื้นฐานในการใช้ยาทุกชนิด) รวมทั้งควรต้องปรึกษาเภสัชกรประจำร้านขายยาก่อนซื้อยาใช้เองเสมอด้วยเช่นกัน
ยาเบต้า-แลคแทมมีปฏิกิริยาระหว่างยากับยาตัวอื่นอย่างไร?
ยาเบต้า-แลคแทมมีปฏิกิริยาระหว่างยากับยาตัวอื่น เช่น
- การใช้ยา Penicillin ร่วมกับยา Methotrexate สามารถเพิ่มระดับยา Methotrexate ในกระแสเลือดให้สูงขึ้นจนอาจก่อให้เกิดอาการข้างเคียงได้ เช่น คลื่นไส้อาเจียน ปากเป็นแผล หากไม่มีความจำเป็นใดๆควรหลีกเลี่ยงการใช้ยาร่วมกัน
- การใช้ยา Cefazolin ร่วมกับยา Amikacin สามารถทำให้เกิดอันตรายกับไตของผู้ป่วยรวมถึงมีอาการบวม น้ำหนักเพิ่ม การหายใจผิดปกติ คลื่นไส้-อาเจียน ควรเลี่ยงและไม่ใช้ยาทั้ง 2 ตัวร่วมกัน
- การใช้ยา Cephalexin ร่วมกับยาลดน้ำตาลในเลือดเช่นยา Metformin อาจเพิ่มฤทธิ์ของยาลดน้ำตาลในเลือด จนเป็นเหตุให้เกิดภาวะน้ำตาลในเลือดต่ำ แพทย์จะปรับขนาดรับประทานให้เหมาะสมเป็นรายบุคคลไป
- การใช้ยา Meropenam ร่วมกับยาแก้ปวด เช่นยา Tramadol ซึ่งยาทั้ง 2 ตัวสามารถกระตุ้นอาการชักในผู้ป่วยได้ หากไม่มีความจำเป็นใดๆควรหลีกเลี่ยงการใช้ยาร่วมกัน
- การใช้ยา Aztreonam ร่วมกับยาเม็ดคุมกำเนิด อาจทำให้ฤทธิ์ของยาคุมกำเนิดด้อยประสิทธิภาพลง ควรใช้วิธีการคุมกำเนิดอื่นเช่น ถุงยางอนามัยชาย การใส่ห่วงคุมกำเนิด ร่วมในการคุมกำเนิดในด้วย
ควรเก็บรักษายาเบต้า-แลคแทมอย่างไร?
ควรเก็บรักษายาเบต้า-แลคแทม เช่น
- กรณีเป็น ยาเม็ด ยาแคปซูล ยาน้ำชนิดแขวนตะกอน (ที่เป็นผง ยังไม่ได้ละลายน้ำ) ยาฉีด
ควรเก็บภายใต้อุณหภูมิ 25 องศาเซลเซียส (Celsius)
- แต่กรณียาน้ำชนิดแขวนตะกอนที่ผสมน้ำแล้วให้เก็บภายใต้อุณหภูมิ 2 - 8 องศาเซลเซียส
- และยาทุกรูปแบบตัวยาควรเก็บ เช่น
- เก็บยาในภาชนะที่ปิดมิดชิด พ้นแสงแดด ความร้อนและความชื้น
- เก็บยาให้พ้น มือเด็กและสัตว์เลี้ยง และ
- ไม่ควรเก็บยาในห้องน้ำ
ยาเบต้า-แลคแทมมีชื่ออื่นอีกไหม? ผลิตจากบริษัทอะไรบ้าง?
ยาเบต้า-แลคแทม มียาชื่อการค้า และบริษัทผู้ผลิตเช่น
| ชื่อการค้า | บริษัทผู้ผลิต |
|---|---|
| Amacin (อะมาซิน) | Asian Pharm |
| Amoxi T.O. (อะม็อกซี ที.โอ.) | T. O. Chemicals |
| Amoxycillin Community Pharm (อะม็อกซีซิลลิน คอมมูนิตี้ ฟาร์ม) | Community Pharm PCL |
| Coamox (คาวม็อกซ์) | Community Pharm PCL |
| Ibiamox (ไอเบียม็อกซ์) | Siam Bheasach |
| Meixil (เมซิล) | Meiji |
| Moxcin (ม็อกซ์ซิน) | General Drugs House |
| Ranoxyl (ราน็อกซิล) | Ranbaxy |
| Servamox (เซอร์วาม็อกซ์) | Sandoz |
| Ammimox (แอมมิม็อกซ์) | MacroPhar |
| Amoxil (อะม็อกซิล) | GlaxoSmithKline |
| Asiamox (เอเซียม็อกซ์) | Asian Pharm |
| Dymoxin (ไดม็อกซิน) | Community Pharm PCL |
| Manmox (แมนม็อกซ์) | T. Man Pharma |
| Moxcillin Charoen Bhaesaj (ม็อกซิลลิน เจริญเภสัช) | Charoen Bhaesaj Lab |
| Moximed (ม็อกซิเมด) | Unison |
| S M Amox (เอส เอ็ม อะม็อกซ์) | S M Pharma |
| Ampicillin General Drugs House (แอมพิซิลลิน เจเนอรัล ดรักซ์ เฮาส์) | General Drugs House |
| Picillin (พิซิลลิน) | MacroPhar |
| Ampicillin T.O. (แอมพิซิลลิน ที.โอ.) | T. O. Chemicals |
| Amicilin (อะมิซิลิน) | Inpac Pharma |
| Ampi Frx (แอมพิ เอฟอาร์เอ็กซ์) | The United Drug (1996) |
| Ampicillin Asian Union (แอมพิซิลลิน เอเซียน ยูเนียน) | Asian Union |
| Ampicillin GPO (แอมพิซิลลิน จีพีโอ) | GPO |
| Ampicillin The Forty-Two (แอมพิซิลลิน เดอะ โฟร์ตี้-ทู) | The Forty-Two |
| Ampicyn (แอมพิซิน) | Siam Bheasach |
| Sia-Mox (ซาย-ม็อกซ์) | Siam Bheasach |
| Ampac (แอมแพค) | Inpac Pharma |
| Ampi T Man (แอมพิ ที แมน) | T. Man Pharma |
| Ampicillin Community Pharm (แอมพิซิลลิน คอมมูนิตี้ ฟาร์ม) | Community Pharm PCL |
| Ampicillin Paediatric (แอมพิซิลลิน พีไดเอทริก) | Utopian |
| Ampicin (แอมพิซิน) | The Forty-Two |
| Cefclor T P (เซฟคลอร์ ที พี) | T P Drug |
| Sifaclor (ซิฟาคลอร์) | Siam Bheasach |
| Distaclor (ดิสทาคลอร์) | DKSH |
| Vercef (เวอร์เซฟ) | Ranbaxy |
| Celco (เซลโค) | Unison |
| Hofclor/Hofclor Forte (ฮอฟคลอร์/ฮอฟคลอร์ ฟอร์ท) | Pharmahof |
| Clorotir (คลอโรเทีย) | Sandoz |
| Tefaclor (เทฟาคลอร์) | T. O. Chemicals |
| Cefute Forte (เซฟุท ฟอร์ท) | T P Drug |
| Cephalexyl (เซฟาเลซิล) | Bangkok Lab & Cosmetic |
| Celex (เซเล็กซ์) | Millimed |
| Cephin (เซฟิน) | General Drugs House |
| Farmalex (ฟาร์มาเล็กซ์) | Farmaline |
| Keflex (เคเฟล็กซ์) | DKSH |
| Sialexin (ซายเล็กซิน) | Siam Bheasach |
| Sporidin (สปอริดิน) | Ranbaxy |
| Ibilex (ไอบีเล็กซ์) | Siam Bheasach |
| Mycef (มายเซฟ) | Unique |
| Sporicef (สปอริเซฟ) | Ranbaxy |
| Toflex (โทเฟล็กซ์) | T. O. Chemicals |
บรรณานุกรม
- https://en.wikipedia.org/wiki/%CE%92-lactam_antibiotic [2022,Jan8]
- https://en.wikipedia.org/wiki/List_of_%CE%B2-lactam_antibiotics [2022,Jan8]
- https://www.mims.com/thailand/drug/info/ampicillin%20t-o- [2022,Jan8]
- https://www.mims.com/Thailand/drug/info/Dicloxacillin%20Medicpharma/ [2022,Jan8]
- https://www.mims.com/Thailand/drug/info/Ranclav/?type=brief [2022,Jan8]
- https://www.mims.com/myanmar/drug/search?q=retarpen+1.2 [2022,Jan8]
- https://www.mims.com/thailand/drug/info/benzathine%20benzylpenicillin?mtype=generic [2022,Jan8]
- https://www.mims.com/Thailand/drug/info/Moxiclav/?type=brief [2022,Jan8]
- https://www.mims.com/thailand/drug/info/cefalexin?mtype=generic [2022,Jan8]
- https://www.mims.com/Thailand/drug/info/Cef-Dime/?type=brief [2022,Jan8]
- https://www.medicinenet.com/cephalosporins-injection/article.htm [2022,Jan8]
- https://www.drugs.com/drug-interactions/folex-pfs-with-penicillin-v-potassium-1590-3015-3610-0.html [2022,Jan8]
- https://www.drugs.com/drug-interactions/amikin-with-cefazolin-153-63-541-0.html [2022,Jan8]
- https://www.drugs.com/drug-interactions/alesse-with-aztreonam-1042-1715-303-0.html [2022,Jan8]